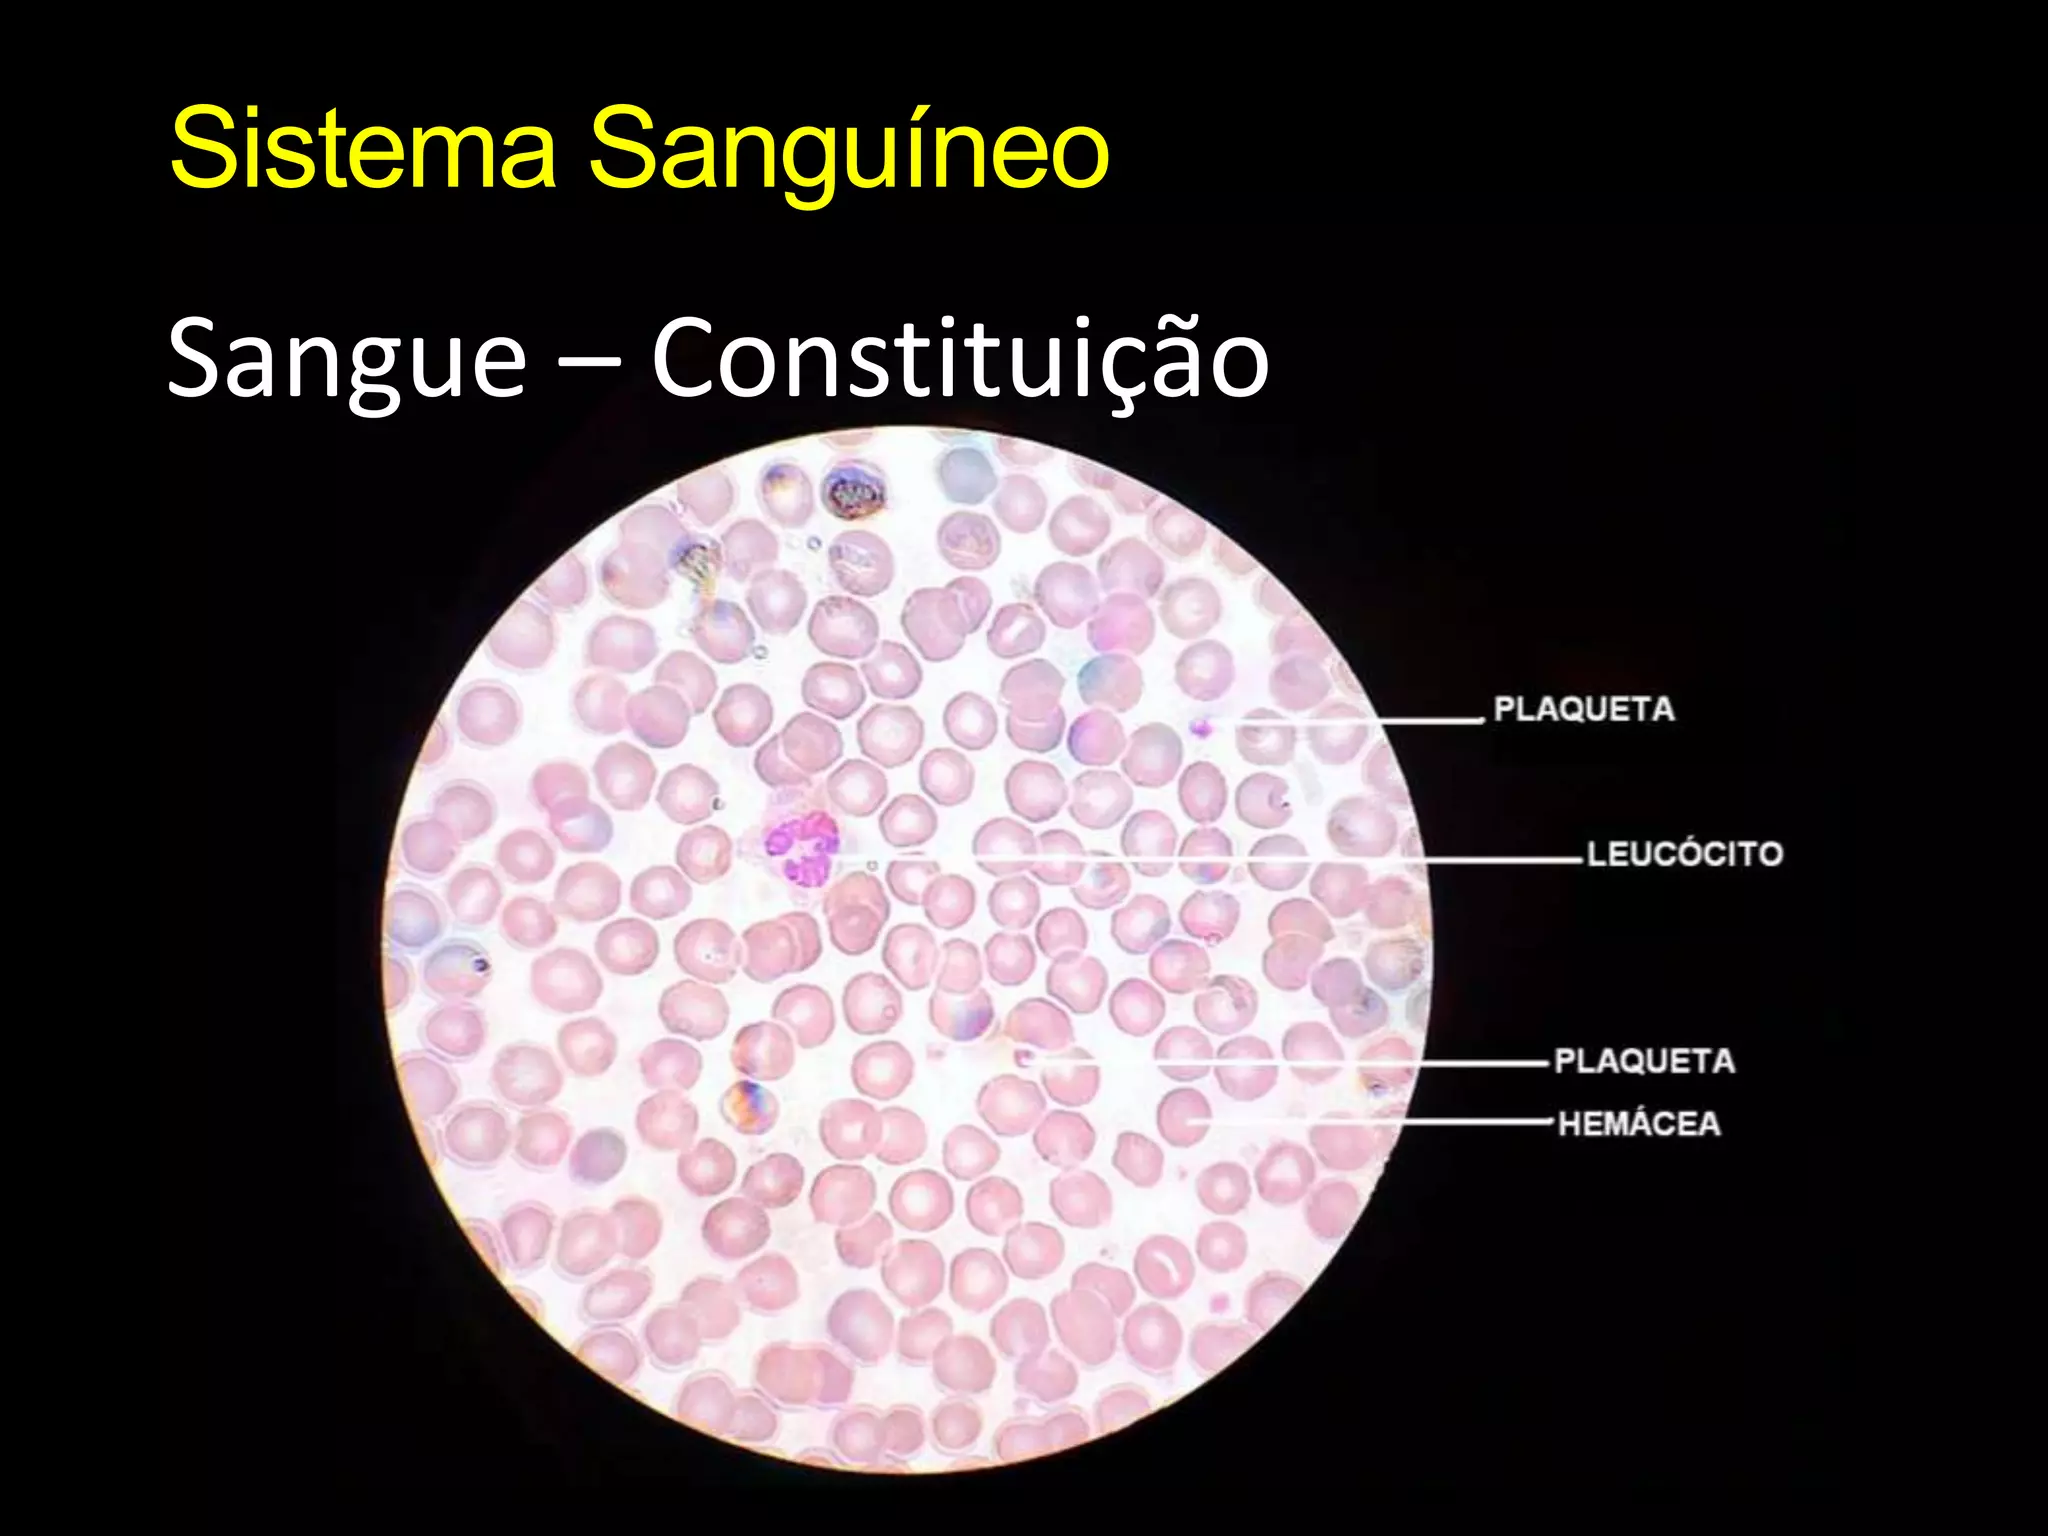
Sistema SanguíneoSangue – Constituição

O documento resume os principais conceitos da anatomia e fisiologia do sistema circulatório humano, incluindo a composição do sangue e dos vasos sanguíneos, o papel do coração e a circulação do sangue através do corpo. Ele também descreve brevemente o sistema linfático, formado por órgãos, nódulos linfáticos e vasos que transportam a linfa.